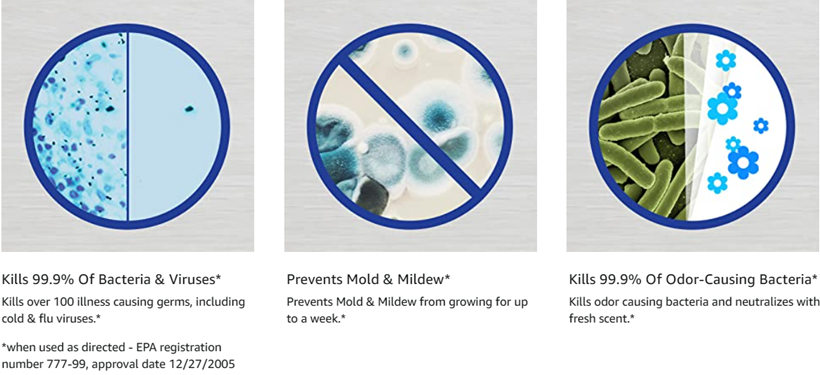

Note: Products with electrical plugs are designed for use in the US. Outlets and voltage differ internationally and this product may require an adapter or converter for use in your destination. Please check compatibility before purchasing.

Lysol Disinfectant Spray kills 99.9% of viruses and bacteria on commonly touched, hard, non-porous surfaces in your home. Help protect your family from germs they could come in contact with every day.
LYSOL Disinfectant Spray CRISP LINEN is an easy, convenient way to freshen your home while protecting your family from harmful germs. This spray eliminates odors and kills 99.9 percent of mildew, mold, viruses, and bacteria on most household surfaces. It can also help prevent common allergies and seasonal colds and flu. And to make your home smell more inviting, LYSOL Disinfectant Spray has crisp fragrance of freshly washed linens drying in the breeze.
Kills 99.9 percent of mildew, mold, viruses, and bacteria with inviting crisp linen scent.
Spray is great for use on kitchen items like sinks, garbage cans, and refrigerator doors.
LYSOL Disinfectant Spray helps protect you and your family from harmful germs and can be used in any room in your home. Spray it in the bathroom on toilet, shower, faucet, and bath surfaces, and in the kitchen on refrigerator doors, sinks, and garbage cans to freshen the air and kill bacteria.
LYSOL Disinfectant Spray is a hospital-grade spray and kills 99.9 percent of viruses, including norovirus, which causes the stomach flu. It also eliminates 99.9 percent of bacteria and fungi, helping to control the growth of mold and mildew, remove odors, and prevent seasonal colds, flus, and allergies.
Use LYSOL Disinfectant Spray to disinfect frequently touched household surfaces like doorknobs, diaper pails, televisions, telephones, remote controls, and light switches. It's also safe to use on soft surfaces like sofas, mattresses, pillows, and bedding.
Simply spray it on--it will deodorize and sanitize the area within 30 seconds. For thorough disinfecting and to prevent mold and mildew, spray enough mist to keep surface wet for 10 minutes and let air dry (rinse toys and food-contact surfaces with water after 10 minutes).
LYSOL Disinfectant Spray CRISP LINEN doesn't just cover up odors. It eliminates them while filling your home with the inviting scent of freshly washed linens.
LYSOL Disinfectant Spray CRISP LINEN (19 ounces, Pack of 3).
Disinfectant Spray
Disinfecting Wipes
Dual Action Disinfecting Wipes